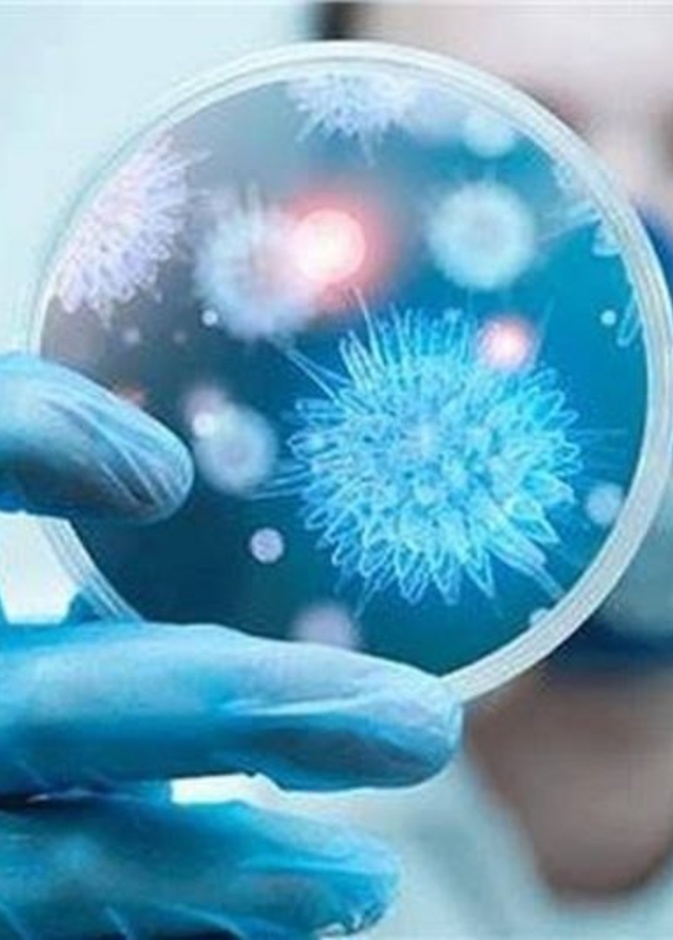
فيروس كورونا الجديد

تأثير الحالة النفسية على الوزن كبير ولافت، فكثير من المشاهير أكدوا أن زيادة وزنهم كانت نتيجة مشاكل نفسية مروا بها
صحة ورشاقة
صحة ورشاقة
آلام أسفل الظهر، أسبابها وطرق علاجها نتعرف عليها في مقابلة "هي" مع الدكتور رضا طلبة من مستشفى كليفلاند كلينك أبوظبي. كما يتطرق الحديث لتقنية "إنتراسبت™" التي تُعدَ علاجاً مبتكراً طفيف التوغل لآلالم أسفل الظهر المزمنة
ماهي الاسعافات الأولية للجلطة القلبية هي مجموعة من الإجراءات التي يمكن إتباعها لتفادي الموت بسببها ومن أهمها الإتصال بالطوارئ وأخذ الأسبرين
طرق الوقاية من الاصابة بقيروس كورونا، اعراض الاصابة بفيروس كورونا، هل الاماكن المزدحمة تتسبب في الاصابة بفيروس كورونا، ما هي خطورة فيروس كورونا على الانسان، السبب الاساسي وراء ظهور فيروس كورونا، نصائح الاطباء لكيفية الوقاية من فيروس كورونا